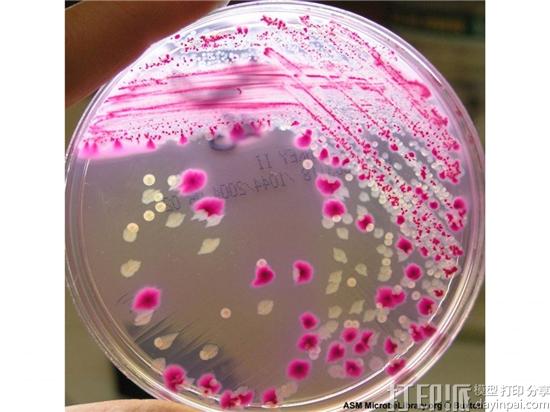
全球七个机构的科学家团队研发出3D打印带血管的肝脏芯片 全球七个机构的科学家团队研发出3D打印带血管的肝脏芯片

dy19932017-09-01 11:49:51
日前,结合了来自哈佛、麻省理工等全球七个机构的科学家团队的最新肝脏组织研究,科学家们结合在3D生物打印、微流体芯片和水凝胶生物支架等多方面的综合知识将体外肝脏药物测试推向了另一个高度。
3D打印的肝脏芯片用于药物测试能够更安全、更可靠的进行,且更适合动物和人类的疾病研究。这项研究的地点集中在哈佛大学医学院和麻省理工学院的卫生科学和技术部门。
根据“纽约时报”2015年发表的数据,每5,000种新的药物成分组合中只有一种能够通过层层测试最终成为批准上市的药物。

由Ali Khademhosseini和Su Ryon Shin带领的科学家团队通过人类细胞的培养从而制造出肝脏芯片,这个芯片的特殊之处不仅仅在于使用的是人类的细胞,还在于拥有匹配的血管结构,可以给组织细胞输送营养。
首先,将人类肝脏细胞(HepG2 / C3A)与凝胶结合以制成组织结构。将藻类的墨水排列打印成肝脏中的血管,随后藻类油墨溶解,在凝胶的中心留下中空通道。使用注射器,将脐静脉内皮细胞(HUVEC)泵入中空通道并呈现血管的形状。引进血流时,通道呈现完全血管化的特征。

然后将该微流体芯片放置在生物反应器内部,保持细胞生长和增殖的恒定条件。实验结果表明,“生物打印血管并与生物反应器的集成有助于创建更接近于现实的肝脏芯片,缩小体外和体内药物测试之间的差距。带血管的肝脏芯片有助于观察和预测微循环水平的药物毒性机制。
在肝脏器官芯片的商业化领域,美国食品药品监督管理局(FDA)已经开始测试一种肝脏芯片。这是一种模拟人类器官生物功能的迷你模型,FDA将测试它是否可以有效地为人体对食物以及食源性疾病的反应建模。这些实验能帮助FDA决定,医药公司在为可能具有毒性的新化合物(如食品添加剂)提出批准申请时,是否可以用芯片数据替代动物试验数据。监管机构尝试用器官芯片替代动物试验,这在全球范围内是首次。

2017年4月11日,FDA食品安全部门的毒理学高级顾问Suzanne Fitzpatrick在一则博客上公布了FDA的这一动向。虽然这类芯片是被设计用于测试药物的,但Fitzpatrick所在的部门也想用它们来试一试单个器官对膳食补充剂和化妆品等产品的反应。他们还能用器官芯片来测试食源性病原体影响特定器官的具体过程。FDA的食品安全科学家们将首先评估人类肝脏芯片,接着会测试肾脏、肺和肠道模型。

这些芯片由位于美国麻省波斯顿市的生物技术公司Emulate制造。这种迷你器官里包含多种人类肝脏细胞,它们长在支架上。类似血液的液体被源源不断地泵入这个系统,为细胞输送营养物质并带走代谢废物。此外,还可以在芯片中添加免疫系统组分,以测试对肝脏新陈代谢的影响。
延伸阅读:哈佛大学用六种“油墨”3D打印出心脏芯片
评论 (0)